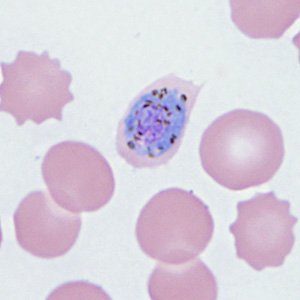
Case410_C.jpg
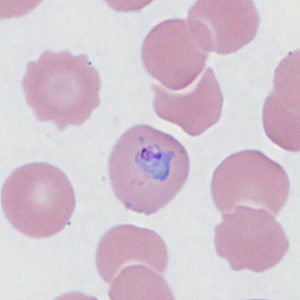
Case410_E.jpg

Case #410 – December 2015
A 22-year-old man, who had traveled to Kenya for a month, developed fever, chills, and general weakness within four days after returning to the U.S. He sought medical attention at a local hospital and admitted to not being fully compliant with taking his anti-malarial medication. Blood smears were ordered, stained with Wright-Giemsa stain, and examined at 1000x magnification with oil. Figures A-I show what was observed on a stained thin smear. What is your diagnosis? Based on what criteria?

Figure A

Figure B
Figure C

Figure D
Figure E

Figure F

Figure G

Figure H

Figure I
DPDx is an educational resource designed for health professionals and laboratory scientists. For an overview including prevention, control, and treatment visit www.cdc.gov/parasites/.